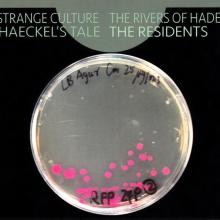

The Cryptic Corporation formed by Jay Clem, [a4173342=John Kennedy], Hardy Fox, and Homer Flynn in 1976. Jay Clem and John Kennedy left the Cryptic Corp. in 1982, Hardy Fox in 2017. Homer Flynn, who is [a6708=The Residents]’ manager, continues to run the corporation.
ALBUMS
The Residents
Wormwood Box
2022, Box, Comp + CD, Album, RE + 2xCD + 2xCD, Album + C, Cherry Red, MVD Audio, New Ralph Too,  ,
,
Leftfield/Experimental/Avantgarde

The Residents / Doc Wör Mirran Featuring Adrian Gormley
Holy Kiss Of Flesh / Songs For Nambia
2022,  ,
,
Experimental/Avantgarde/Darkwave/Downtempo/Dark Jazz/Abstract

The Residents
Cube-E Box (The History Of American Music In 3 E-Z Pieces)
2020, Box + 6xCD, Album, RE, RM + CD, RM, New Ralph Too, Cherry Red, MVD Audio, 

 ,
,
Avantgarde/Experimental

The Residents & Renaldo & The Loaf
Title In Limbo + 4 Daze
2017,  ,
,
Alternative Rock/Experimental/Post Rock

Randy Rose
For Maurice
2016, 7", S/Sided, Etch, Ltd, Num, Pin, Psychofon Records,  ,
,
Experimental

The Residents
Sculpt, A Film By Loris Gréaud
2016, CDr, Comp, Ltd, Num, Not On Label (The Residents Self-released),  ,
,
Abstract/Soundtrack

Marcel Dettmann
DJ-Kicks
2016,  ,
,
Techno/Industrial/Electro/House/Experimental

Randy Rose
Bigfoot Beware
2016,  ,
,
Experimental

The Residents
Strange Culture / The Rivers Of Hades / Haeckel's Tale
2015,  ,
,
Experimental/Ambient/Soundtrack
The Residents
Shadowland
2015,  ,
,
Experimental

The Residents
The Snakey Wake
2015,  ,
,
Experimental

The Residents
Whatever Happened To Vileness Fats? / The Census Taker
2014, CD, Album, Comp, MP, MVD Audio,  ,
,
Avantgarde/Experimental/Soundtrack

The Residents
The 12 Days Of Brumalia + Prelude To "The Teds"
2014, CD, Comp, MVD Audio,  ,
,
Avantgarde/Experimental

The Residents
The Wonder Of Weird
2014,  ,
,
Experimental

Charles Bobuck
The Highway
2014,  ,
,
Experimental

The Delta Nudes*
Greatest Hiss
2013,  ,
,
Experimental

The Residents
Mush-Room
2013,  ,
,
Abstract/Avantgarde

The Residents
Heaven? / Hell!
2012, 2xCD, Comp, Ltd, RE, Cryptic Corporation,  ,
,
Experimental

The Residents
Night Train To Nowhere!
2012, CD, Ltd, Not On Label (The Residents Self-released),  ,
,
Experimental

Charles Bobuck
Maxine
2012, File, MP3, 320, RSD,  ,
,
Experimental/Ambient

Th* R*sidents*
D*ck S*ab 35th Anniversary
2012, CDr, Cryptic Corporation,  ,
,
Experimental

The Residents
Eskimo
2012,  ,
,
Experimental/Ambient/Tribal

The Residents
Demonic! The Residents Live In Oslo!
2012,  ,
,
Avantgarde/Experimental

Charles Bobuck
Chuck's Ghost Music
2012,  ,
,
Avantgarde/Experimental

Charles Bobuck
Codgers On The Moon
2012,  ,
,
Experimental

Charles Bobuck
Lying Horse Rock
2012,  ,
,
Experimental

Charles Bobuck
GOD O: Music For A Gallery Opening
2012,  ,
,
Ambient

The Residents
Bad Day On The Midway (Music From The Game Reconsidered)
2012,  ,
,
Experimental

The Residents
Talking Light Bimbo's
2011, 2xCDr, Album, Ltd, Ralph Records,  ,
,
Avantgarde/Experimental

The Residents
Talking Light: Bimbo's
2011, DVD-V, NTSC, MVD Visual, Cryptic Corporation,  ,
,
Experimental

The Residents
The Rivers Of Hades
2011,  ,
,
Experimental

The Residents Present Sonidos De La Noche
Coochie Brake
2011,  ,
,
Avantgarde/Experimental

The Residents
Ozark
2011,  ,
,
Abstract/Avantgarde/Experimental

The Residents
Lonely Teenager
2011,  ,
,
Abstract/Avantgarde/Experimental

The Residents
Talking Light Live In Rehearsal, Santa Cruz, California
2010, CD, Album, Ltd, RSD,  ,
,
Abstract/Experimental

The Residents
Brava
2010, CDr, Album, Ralph Records,  ,
,
Avantgarde/Experimental

The Residents
Lost In A Vacant Lot
2010, CDr, Comp, Ralph Records,  ,
,
Abstract/Experimental

The Residents
Randy's Ghost Stories
2010,  ,
,
Avantgarde/Experimental

The Residents
Ten Little Piggies
2009, CD, Comp, MVD Audio,  ,
,
Soundtrack/Art Rock/Experimental

The Residents
Is Anybody Out There?
2009, DVD-V, NTSC, MVD Visual, Cryptic Corporation,  ,
,
Abstract/Monolog/Experimental

The Residents
Arkansas
2009, CD, Album, Ltd, Num, Ralph America,  ,
,
Avantgarde/Experimental

The Residents
The Knife Fight
2009, CD, Ltd, Num, Promo, Not On Label (The Residents Self-released),  ,
,
Avantgarde/Experimental

The Residents
The UGHS!
2009,  ,
,
Free Jazz/Downtempo/Experimental

The Residents
Animal Lover Instrumental
2008, CD, Album, Ltd, Num, Ralph America,  ,
,
Ambient/Experimental

The Residents
The Bunny Boy
2008,  ,
,
Avantgarde/Experimental

The Residents
Best Left Unspoken... Volume Two: High Horses And Other Selections
2007, CD, Comp, Ltd, Num, Ralph America,  ,
,
Abstract/Experimental

The Residents
Best Left Unspoken... Volume Three: For Elsie And Other Selections
2007, CD, Comp, Ltd, Num, Ralph America,  ,
,
Abstract/Experimental

The Residents
The Voice Of Midnight
2007, 

 ,
,
Abstract/Radioplay/Experimental

The Residents
Night Of The Hunters
2007,  ,
,
Ambient/Experimental/Tribal

The Residents
Cube-E
2006, Box + DVD + 2xCD, Album, Ltd, Num, Ralph America,  ,
,
Avantgarde/Experimental

The Residents
Best Left Unspoken... Volume One: Pollex Christi And Other Selections
2006, CD, Comp, Ltd, Num, Ralph America,  ,
,
Abstract/Experimental

The Residents
Tweedles!
2006,  ,
,
Experimental

The Residents
Mark Of The Mole & Intermission
2005, CD, Album, Enh, RE + CD, EP, Enh, RE + Comp, Mute, Mute, Mute, 

 ,
,
Avantgarde/Experimental

The Residents
The Tunes Of Two Cities & The Big Bubble
2005, CD, Album, Enh, RE + CD, Album, Enh, RE + Comp, Mute, Mute, Mute, 

 ,
,
Avantgarde/Experimental

The Residents
The Residents Play Wormwood
2005,  ,
,
Avantgarde

The Residents
Disfigured Night
2004,  ,
,
Avantgarde/Experimental

The Residents
The 12 Days Of Brumalia
2004,  ,
,
Avantgarde/Experimental

The Residents
WB:RMX
2004,  ,
,
Avantgarde/Experimental

The Residents
Commercial Album DVD
2004, 
 ,
,
Experimental

The Residents
Kettles Of Fish On The Outskirts Of Town
2003, DVD-V, NTSC + 3xCD, Comp, Euro Ralph,  ,
,
Abstract/Avantgarde/Experimental

The Residents
Demons Dance Alone DVD
2003,  ,
,
Avantgarde

The Residents
Live! ...On The Outskirts
2002, DVD-V, Ltd, Multichannel, NTSC, Euro Ralph,  ,
,
Experimental

The Residents
Eskimo
2002,  ,
,
Tribal/Avantgarde

The Residents
Petting Zoo
2002,  ,
,
Experimental

The Residents
Eat Exuding Oinks! Ralph Records' 1977 Radio Special
2002,  ,
,
Avantgarde/Experimental

The Residents
Icky Flix
2001,  ,
,
Experimental

The Residents
Icky Flix (Original Soundtrack Recording)
2001,  ,
,
Experimental

The Residents
God In Three Persons
2000,  ,
,
Experimental

The Residents
Assorted Secrets
2000,  ,
,
Abstract/Experimental

The Residents
Diskomo 2000
2000,  ,
,
Avantgarde/Experimental/Synth-pop

The Residents
Roadworms (The Berlin Sessions)
2000,  ,
,
Experimental

The Residents
Dot.Com
2000,  ,
,
Abstract/Experimental

The Residents
Wormwood Live 1999
1999, 2xCD, Album, Ltd, Num, Ralph America,  ,
,
Avantgarde/Experimental

The Residents
George & James
1999,  ,
,
Experimental

The Residents
Refused
1999,  ,
,
Avantgarde/Experimental

The Residents
I Hate Heaven
1998, CD, Promo, Euro Ralph,  ,
,
Experimental

The Residents
Twenty-Five Years Of Eyeball Excellence
1998, CD, Comp, RM, Bomba Records (4),  ,
,
Abstract/Avantgarde/Experimental

The Residents
Residue Deux
1998,  ,
,
Abstract/Art Rock/Experimental/Avantgarde

The Residents
Live At The Fillmore
1998,  ,
,
Abstract/Experimental

The Residents
Intermission
1998,  ,
,
Experimental

The Residents
Wormwood (Curious Stories From The Bible)
1998,  ,
,
Leftfield/Experimental

The Residents
The Mole Show Live At The Roxy
1998,  ,
,
Leftfield/Art Rock/Avantgarde

The Residents
Pollex Christi
1997,  ,
,
Experimental/Modern Classical

The Residents
Freak Show
1994,  ,
,
Synth-pop/Experimental

The Residents
Gingerbread Man
1994,  ,
,
Experimental

The Residents
Gingerbread Man (Expanded Album)
1994,  ,
,
Experimental

The Residents
Prelude To "The Teds"
1993, CD, EP, Hello Recording Club,  ,
,
Experimental

The Residents
Uncle Willie's Highly Opinionated Guide To The Residents
1993,  ,
,
Abstract/Avantgarde/Experimental

The Residents
Twenty Twisted Questions
1992,  ,
,
Abstract/Experimental

The Residents
Our Finest Flowers
1992,  ,
,
Experimental

The Residents
Whatever Happened To Vileness Fats?
1991,  ,
,
Soundtrack/Experimental

The Residents
The Eyes Scream: A History Of The Residents
1991,  ,
,
Experimental

The Residents
Freak Show Video Press Release
1991,  ,
,
Experimental

The Residents
Diskomo
1990,  ,
,
Experimental/Disco

The Residents
Cube-E (The History Of American Music In 3 E-Z Pieces) - Live In Holland
1990,  ,
,
Experimental

The Residents
Freak Show
1990,  ,
,
Experimental

The Residents
Don't Be Cruel
1990,  ,
,
Experimental

The Residents
The King & Eye
1989,  ,
,
Blues Rock/Experimental

The Residents
Mole Show (Live In Holland June 6th 1983)
1989,  ,
,
Experimental

The Residents
Buckaroo Blues & Black Barry
1989,  ,
,
Experimental

The Residents
Diskomo - Live In San Francisco
1988, Flexi, 6", Shape, S/Sided, Reflex Magazine,  ,
,
Experimental

The Residents
Mark Of The Mole
1988,  ,
,
Experimental

The Residents
Holy Kiss Of Flesh
1988,  ,
,
Synth-pop/Experimental

The Residents
The Tunes Of Two Cities
1988,  ,
,
Experimental

The Residents
Double Shot
1988,  ,
,
Synth-pop/Experimental

The Residents
13th Anniversary Show - Live In Japan / Stars & Hank Forever
1987, Cass, Album, Comp, Ginger Music, Ginger Music,  ,
,
Avantgarde

The Residents
Video Voodoo Volume I
1987,  ,
,
Avantgarde/Experimental

The Residents Featuring Snakefinger
Live In Holland (13th Anniversary Show)
1987,  ,
,
Experimental

The Residents
Duck Stab
1987,  ,
,
Avantgarde/Experimental

The Residents
Hit The Road Jack (Special Almost Dance Mix)
1987,  ,
,
Synth-pop/Experimental

The Residents
Fingerprince
1987,  ,
,
Experimental

The Residents
The Third Reich 'N' Roll
1987,  ,
,
Experimental/Parody

The Residents Featuring Snakefinger
13th Anniversary Show - Live In Japan
1986,  ,
,
Experimental

The Residents
Stars & Hank Forever! (The American Composer's Series - Volume II)
1986,  ,
,
Experimental

The Residents
Hell!
1986,  ,
,
Experimental

The Residents
Heaven?
1986,  ,
,
Experimental

The Residents Featuring Snakefinger
Live In The USA! 13th Anniversary Tour
1986,  ,
,
Abstract/Avantgarde/Experimental

The Residents
Memorial Hits
1985, LP, Comp, Wave (7), Ralph Records,  ,
,
Abstract/Minimal/Experimental

The Residents
The Big Bubble (Part Four Of The Mole Trilogy)
1985,  ,
,
Experimental

Various / Penn Jillette
Ralph Records 10th Anniversary Radio Special!
1982,  ,
,
Alternative Rock/Spoken Word/Avantgarde/Art Rock/Comedy/Synth-pop/Experimental

APPEARANCES +
The Residents
The Way We Were
2005,  ,
,
Avantgarde/Experimental

The Residents
Leftovers Again?!
2021, 

 ,
,
Avantgarde/Experimental

The Residents
In Between Dreams (Live In San Francisco)
2020,  ,
,
Experimental

The Residents
Mole Box
2019, 6xCD, RM + Box, Comp, New Ralph Too, Cherry Red, MVD Audio, 

 ,
,
Avantgarde/Experimental

The Residents
A Nickle If Your Dick's This Big
2019, 2xCD, Album, Comp, Mono, RM, New Ralph Too, Cherry Red, MVD Audio, 

 ,
,
Acoustic/Art Rock/Avantgarde/Experimental

The Residents
Not Available
2019, 

 ,
,
Avantgarde/Experimental

The Residents
Eskimo
2019, 

 ,
,
Avantgarde/Experimental

The Residents
Commercial Album
2019, 

 ,
,
Avantgarde/Experimental

Various
Additive Noise Function
2019,  ,
,
Industrial/Minimal/Experimental

The Residents
I Am A Resident!
2018,  ,
,
Alternative Rock/Avantgarde/Experimental

The Residents
Duck Stab / Buster & Glen
2018, 

 ,
,
Avantgarde/Experimental

The Residents
I Am A Resident!
2018,  ,
,
Alternative Rock/Avantgarde/Experimental

The Residents
Disfigured Night
2016, CD, Album, Comp, Klanggalerie,  ,
,
Avantgarde/Experimental

The Residents
Theory Of Obscurity - A Film About The Residents
2016,  ,
,
Abstract/Avantgarde

The Residents
Wormwood
2015,  ,
,
Experimental

The Residents Feat. Snakefinger
Live In The USA - 13th Anniversary Show
2015,  ,
,
Avantgarde/Experimental

The Residents
The King & Eye: RMX
2004,  ,
,
Leftfield/Experimental

The Residents Featuring Snakefinger
13th Anniversary Show - Live In Tokyo!
1999,  ,
,
Experimental

The Residents
Freak Show CD-ROM Video Tour
1994, VHS, PAL, Ralph America,  ,
,
Avantgarde/Experimental

The Residents
Meet The Residents
1977,  ,
,
Experimental

The Residents
Fingerprince
1977,  ,
,
Experimental

The Residents
Icky Flix
2006,  ,
,
Experimental

The Residents
Tweedles!
2006,  ,
,
Experimental

The Residents
Freak Show
2001,  ,
,
Experimental

The Residents
Hell!
2000,  ,
,
Experimental

The Residents Featuring Snakefinger
13th Anniversary Show - Live In Tokyo
1999,  ,
,
Experimental

The Residents
The King And I
1999,  ,
,
Experimental

The Residents
Cube-E
1999,  ,
,
Experimental

The Residents
Our Finest Flowers
1999,  ,
,
Experimental

The Residents
Cube E: The History Of American Music In 3 E-Z Pieces - Piece 3: The Baby King
1990, LP, Unofficial, The Disk Jockey Association,  ,
,
Abstract/Experimental

The Residents
George & James
Experimental
The Residents
Gingerbread Man
Experimental
The Residents
Whatever Happened To Vileness Fats?
Soundtrack/Avantgarde/Experimental

The Residents
Wormwood (Curious Stories From The Bible)
Experimental/Abstract

The Residents
Icky Flix (Original Soundtrack Recording)
Experimental/Abstract
